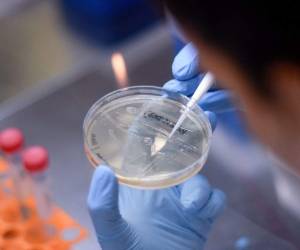

“Porque estaba enfermita”, responde José Collantes Navarro, con la poca compostura que le queda.
Ahora no llora, pero en otros momentos este peruano de 36 años que lleva ocho viviendo en Chile no logra contener las lágrimas. “No vayas a llorar”, le reitera a menudo su pequeña Kehity.
LEA TAMBIÉN: Más de 904,000 muertos por coronavirus en el mundo
La nena —explica su padre a The Associated Press— no ha llorado desde que su mamá se infectó del nuevo coronavirus y murió a mediados de junio. La respuesta que le repite a su hija es la más evidente, pero ni a él mismo le basta: ¿por qué está muerta? ¿Fue el covid-19 o hubo fallas en los cuidados hospitalarios que recibió? ¿Por qué si él y Kehity también se contagiaron, sólo ella falleció?
Su historia no dista mucho de la de otras víctimas de covid. Se sabe que en una misma familia algunos enferman y otros no. Algunos tienen síntomas y otros no. En algunos infectados, dependiendo diversos factores, el daño y el deterioro puede ser rápido y en otros no. Algunos se recuperan; otros, no. Sin embargo, esto no es consuelo para José y su caso visibiliza la tristeza y las preguntas que le quedan a quien pierde a un ser querido por la enfermedad. Para algunos, la tragedia no termina cuando el virus abandona su cuerpo.
El tiempo sólo aumenta las dudas. La mujer de José —Silvia Cano Campos, también peruana, de 37 años— estaba bien a principios de mayo y ahora ya no está. Su vida sigue rota y no logra repararla. ¿Cómo seguir sin ella?
Como él, otras 15,000 familias perdieron a sus seres queridos en Chile por covid-19 y la mayoría no pudo despedirse ni realizar funerales.
DE INTERÉS: Las diez etapas clave de la pandemia del covid-19
José fue el primero en contagiarse. Tras contraer el virus a fines de abril, se confinó en una residencia sanitaria para proteger a su mujer y a Kehity. Los síntomas —dolor de cuerpo y cabeza— no lo agobiaron demasiado y la pareja se reencontró el 12 de mayo, cuando José fue a buscar a Silvia a su trabajo tras salir del confinamiento.
“La vi como mal. Me dijo que tenía mucho dolor en la espalda”, cuenta el electricista.
Aludiendo al efecto leve que el virus tuvo en él le dijo a su mujer que “el coronavirus no hace nada”, y bajo la suposición de que Silva pudiera haberlo contraído le dio un remedio casero: agua caliente con eucalipto.
El dolor aumentó y cinco días después fueron a un centro médico en la empobrecida barriada La Cisterna, donde le diagnosticaron un resfrío y la devolvieron a casa.
“No aguanto la espalda, me cuesta respirar”, le decía Silvia.
El 19 de mayo regresaron y le detectaron síntomas compatibles con neumonía, por lo que la derivaron al Hospital Barros Luco Trudeau, que atiende a 1,3 de los ocho millones de habitantes del gran Santiago. Ésa fue la última vez que José la vio con vida.
LEA: Es improbable que vacuna contra covid pueda estar lista en noviembre
Aquella semana, Chile promediaba 4.000 nuevos contagiados y 40 muertos diarios y el porcentaje de ocupación de las camas de los hospitales de Santiago bordeaba entre 95% y 100%, según la Sociedad Chilena de Medicina Intensiva.
El Ministerio de Salud afirmaba que el número de contagiados obedecía a la realización de muchos exámenes para detectar el virus aunque luego admitió que falló en el seguimiento de contagiados y sus contactos. Expertos en Salud afirman que también fracasaron las cuarentenas, que se imponían y levantaban en cuestión de semanas y no impidieron la transmisión. No fue sino hasta medidos de mayo, por ejemplo, que se impuso una cuarentena que afectó la movilidad de todo el gran Santiago.
Durante la segunda quincena de mayo y la primera de junio, los contagios parecían imparables. Los hospitales públicos y privados triplicaron las camas de uso crítico y las instalaron fuera de las Unidad de Cuidados Intensivos (UCI) en urgencias, pabellones y en las UCI pediátricas. Además, las máquinas de anestesia se usaban como ventiladores mecánicos y se compraron centenares de respiradores en el extranjero.
Para trasladarse a la clínica, la pareja tuvo que usar su propio vehículo, pues el sistema de Salud estaba tan saturado que en aquellos días las ambulancias demoraban horas formadas afuera de las salas de urgencias en espera de que sus pacientes recibieran atención.
José afirma que, tras hospitalizarla, pasó seis días sin noticias de Silvia. “Perdí totalmente comunicación con el hospital”, aunque mantenían contacto por celular.
En una de las llamadas, su mujer le explicó cómo cocinar una especie de pan que comería con Kehity. Ésa fue la primera vez que José empezó a hacerse cargo de las labores hogareñas y ahora incluso le enseña a su hija cómo prepararse para cuando pueda volver a la escuela.
Su trabajo como electricista estuvo en pausa desde abril por las cuarentenas. Ahora, como sólo recibe un seguro decreciente de cesantía —que inició en unos 540 dólares y llegó a 230 en agosto—, reparte productos a domicilio para una compañía de transportes, lo que le permite llevar a Kehity con él. En la segunda semana de septiembre retornó por horas a su trabajo.
Ambos viven con la hermana de José, que trabaja de noche, por lo que no puede apoyarlo mucho con la niña. Él quiere traer a un familiar de Perú para que lo ayude, pero debe esperar a que reabran las fronteras.
La primera llamada que recibió del hospital fue el 25 de mayo cuando le informaron que Silvia estaba en la Unidad de Tratamientos Intensivos “con un importante compromiso en la parte pulmonar”. Cuatro días después le informaron que había sido ingresada a la UCI y se le conectó a un ventilador. Según José, preguntó a un médico si su pareja había llegado demasiado tarde y él respondió: “simplemente llegó demasiado grave”.
LEA: Fauci: Pausa en pruebas de vacuna es 'válvula de seguridad'
A José le cuesta entender el avance del covid-19 en el cuerpo de Silvia. Si ingresó caminando al hospital, ¿por qué después le fue imposible respirar por sí misma?
Durante la comunicación con el médico, José pidió ver a su mujer. “Yo estuve contagiado', le dijo. 'A mí no me importa, quiero estar con ella... Nunca me dejaron, nunca ni una videollamada”.
Aunque Kehity —nacida en Chile— no presentó síntomas, también se contagió. Se enteraron en agosto, tras una prueba que reveló la presencia de los anticuerpos que desarrollan quienes tuvieron COVID-19.
Con el paso de los días, José recibió más llamadas del hospital. Cada una le repetía: Silvia está grave. Para José, incluso ahora, una pregunta persiste: ¿cuándo se agravó? Sólo una doctora le dio una pista: “ella siempre ha estado de extrema gravedad”.
“¿Por qué no se dieron cuenta a tiempo que ella se estaba agravando?”, se pregunta.
En las siguientes comunicaciones hubo mensajes contradictorios que inicialmente lo aliviaron y luego le destrozaron la vida.
Cuando Silvia llevaba dos semanas en la UCI, un médico le dijo a José que estaba estable —aunque grave— porque uno de sus pulmones había mejorado y se evaluaría el retiro del ventilador. El peruano estaba feliz. Al día siguiente, 14 de junio, fue a trabajar en un piso de cemento porque pensó que necesitaría dinero para la recuperación. Sin embargo, a media mañana recibió la llamada que lo cambió todo: una doctora le pedía que fuera rápido al hospital.
Al llegar a la UCI, donde le ofrecieron ver a su mujer para despedirse, José dice haber cuestionado cómo era posible que Silvia estuviera muriendo si el día anterior le dijeron que mejoraba. Al final aceptó la excepción que se le ofrecía y lo llevaron a ver a Silvia.
Chile es uno de los pocos países de América Latina que ha permitido a familiares despedirse de sus seres queridos en caso de haber contraído el virus. Argentina empieza a permitirlo en algunas clínicas.
“Mi esposa no se estaba muriendo', asegura José. 'Ella estaba muerta, estaba congelada”.
El mismo día fallecieron otras 221 personas por covid en el país. En esa jornada Chile registró su más alto nivel de contagios hasta el momento: 6.938.
¿Por qué murió su mujer? José se repite la pregunta que le hace su hija una y no encuentra consuelo.
En busca de respuestas, regresó al hospital dos días después. Asegura que un médico le dijo que “él no sabía quién era el doctor que atendió a mi esposa”, por lo que contactó a un abogado para que le ayude a averiguar qué pasó. Su objetivo, dice, es obtener una “explicación” de todos los especialistas que la atendieron y que multen al hospital “si es que hubo alguna falla”. Afirma que no busca dinero, sino saber qué pasó.
El hospital, consultado por AP, declinó referirse a lo sucedido.
Tras la muerte de Silvia, el hospital le entregó su historial médico y entre los papeles está el resultado de una prueba de imagen que le hicieron el 25 de mayo. De acuerdo a José, su prima —que trabaja en una clínica privada— se lo mostró a un doctor que dijo que en ese momento tenía el 80% de los pulmones destruidos.
“Me dice (que) no iba a vivir... o si un milagro la salvaba, ella iba a vivir con una secuela de por vida”, cuenta.
Su tristeza no concluyó con la muerte de Silvia: como muchos otros que pierden a sus seres queridos por COVID, tuvo que enfrentar el calvario de su entierro. Aunque él esperaba cremarla por petición de la familia, pasaron dos semanas sin que obtuviera los permisos y durante aquel tiempo el cuerpo de Silvia permaneció en una cámara frigorífica. Horrorizado de imaginarla en esas condiciones, se dio por vencido y decidió enterrarla en un “patio social” del Cementerio Católico.
Ahora la tumba está cubierta por las flores que José busca para ella y la visita al menos una vez por semana.
“No quiero rendirme”, dice José, que no ha pensado en regresar a Perú.
Con la mirada triste dice que más que por él, lo hace por Kehity. Para, algún día, “darle una explicación a mi hija”.